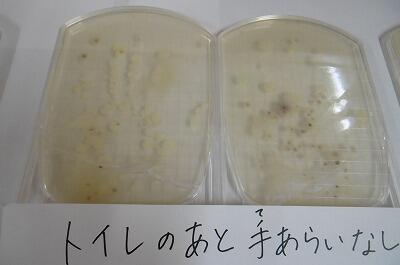

お知らせ/学びの丘日記
体育はドラマだ!
ということで、題して「体育はドラマだ!」
ご覧ください!

まずは、小学部6年生「跳び箱」の授業の様子からです。



より高く、かっこいいフォームで跳べたとき、笑顔がはじけました!

4年生は、長縄の「八の字跳び」に挑戦中です。

心を一つに跳び続け、見事、連続跳びの記録を更新し、クラスみんなで喜び合っていました。私もその場に立ち会えて、すごく感動しました!

~つづく~
今日の給食(1/21)
〇麦ご飯、牛乳
〇カツカレー(トンカツ)
〇ブロッコリーサラダ

来週から中学3年生の入学試験が始まります。試験に「勝つ!」ということで、今日の給食は・・・

【カツ!カレーです!】

【それでは、受験生のみなさん!試験に~~~~】

【勝つ!!】

【勝つ!!】

【絶対勝つ!!】
~DO YOUR BEST!
 ~
~ 協和・向上を目指して・・・

1月20日、小学部高学年、中学部が参加する全校専門委員会が開かれました。
テーマは、3学期、上学をもっともっとよくしていくための「具体策」の検討です。
各委員会の話合いの様子をご覧ください。


【文化・広報委員会】
テーマ
〇卒業式や終業式で最高の歌声を響かせよう。
〇卒業生に感謝の気持ちを伝えよう。


【保体給食委員会】
テーマ
〇マナーを守り、感謝して食べよう。
〇新型コロナウイルス感染症を予防しよう。


【学習・図書委員会】
テーマ
〇家庭学習を充実させよう。


【生活美化委員会】
〇身の回りの整理整頓をしよう。
どの委員会も、上学みんなで協和し、向上していこうという熱を感じる話合いがもたれていました。
*人権委員会については、2月に行われる「人権集会」の準備を行っていました。詳しくは「人権集会の様子」の時にお伝えします。
税の大切さを学ぶ・・・

憲法に定められている「納税の義務」
小学部6年生、税金の大切さについて学ぶ「租税教室」の様子をお伝えします。

【お忙しい中、税務課から2名の方に来ていただきました。】
まずは、子ども達にとって、1番身近な税である消費税について・・・

【「消費税」は、何%か知っている人?】
では、もし税金がなかったら・・・

【DVD視聴・・・。町はゴミだらけ、道路も整備されず、火事や犯罪が起こっても・・・。(税の大切さについて、とても分かりやすい動画でした。)】

【もう一度問います!税金は、必要ですか?】


最後に、考えを交流し、教室を終えました。
税金はなぜ必要なのか、どんなことに税金が使われているのか、教科書だけではなかなか実感がもてない内容ですが、この教室によって、正しい理解につながったと思います。
税務課の皆様、貴重な教室を開催していただき、誠にありがとうございました。
【番外編】

【よくドラマ等で登場するジュラルミンケース。中身は・・】

【じゃ~~~~ん!!なんと1億円!!のレプリカ・・・。(お金について、もっと知ってもらうために、持ってきてくださいました。)】

【1億円に殺到する子ども達・・・。コラコラ、落ち着きなさい!】

【先生!めちゃくちゃ重いです!の名(迷)演技?でも、およそ10kgあるそうです。】

【力持ちの君が持つと、「出前のおかもち」みたいだね!
 】
】~おしまい~
今日の給食&授業の様子(1/20)
〇麦ご飯、牛乳
〇肉じゃが
〇納豆サラダ


今日の小さいおかずは、みんな大好き!?
 納豆サラダ。
納豆サラダ。納豆はタンパク質やカルシウム、食物繊維が豊富なんですよ!

【このネバネバや匂いが苦手な人も・・・、体にいいんです!】

【ネバーギブアップ!!
 】
】 【授業の様子】

中学部2年、技術の授業の様子です。


【設計図を見ながら、一生懸命何を作っているのでしょうか?】

【ドライバーを巧みに操り、何を作っているのでしょうか!?】

【NO.1に完成した生徒を発見!】

【手回し充電ラジオでした~!(懐中電灯付き)もしもの時でも重宝されるし、一石二鳥の学習でしたね!】
小さな旅⑱
まずは小学部1年生・・・

【朝の歌を楽しそうに歌っていました。さぁ、この踊りから何の歌を歌っているのか分かりますか?】

【わかりましたね?!「パプリカ♪」です!】
次は、旅をしなくても職員室にやってきてくれました。

【おもいっきり遊びたい昼休みなのに・・・。並んでいるのは小学部2年生。何をしているのかというと・・・、(説教タイムではありません・・
 。)】
。)】
【かけ算九九の試験です!】

【二一が二、二二んが四、二三が六・・・・スラスラ言えたね!。みんな、「かけ算九九ゴールド免許」目指し、がんばっています!!】
朝、小学部3年生以上は、卒業式の歌の練習。

【3年生は校歌の練習】
5年生、6年生は、「いのちの歌♪」の練習。

【5年生】

【6年生】
とても明るく、優しい6年生が卒業すると思うと・・・。少し寂しい気持ちになりました・・。

~つづく~
今日の給食&授業の様子(1/19)
〇黒糖パン、牛乳
〇冬野菜スープ
〇ハンバーグ&きのこソース

冬野菜には、大根などの根菜類や小松菜、ほうれん草、白菜などの葉野菜とたくさんの種類がありますね。
冬野菜は、寒い気候に耐えているので甘みが強く、体を温める効果があるそうです。冬野菜をたくさん食べて、元気な体をつくりましょう!
【授業の様子】

5年体育「バスケットボール」の授業です。

みんながゲームを楽しめるようにルールを工夫しながら行っていました。

いつもアクティブ!英語の授業です。

今回は、中学部1年生の教室にお邪魔しました。


英文をジェスチャーを交えながら伝えていきます。

生徒も先生も、みんな楽しそう!

今日の給食&上学ニュース!(1/18)
〇麦ご飯、牛乳
〇鶏肉と大豆の煮物
〇ほうれん草とコーンの和え物

今日の大きいおかずには・・・

【大豆、鶏肉がたっぷり!小さいおかずには・・・】

【ポパイも大好きほうれん草!!筋肉が喜んでいます!
 】
】【上学ニュース!】

今日から2日間、小学部は、CRTテストです。
CRTは、学年の学習内容をどのくらい理解できているかをみるためのテストです。


【今日は国語のテスト。しっかり問題文を読んで答えていました。しかし・・・】

【「時間との戦い」でもあります。速く正確に読み取る力が必要です!】
CRTの結果や分析したものを、2月の参観日に保護者にお渡しする予定です。
一方、中学部は・・・

【明日は、レベコン(レベルアップコンテスト)です。】
学年のまとめの3学期、一人一人の学力向上を目指し、小学部・中学部ともに、しっかり取り組んでいきます。
子どもは風の子・・・
それでもやはり「子どもは風の子!元気な子!」
ご覧ください。

【外を駆け回る1年生。何をしているのかというと・・・】


【一生懸命作った風車を・・・、*撮影時のみマスクを外しています。】

【走って・・・】

【走って、走って・・・。寒風に立ち向かうように・・・】

【笑顔いっぱい走り続けていました。
 】
】続いては、寒い寒い1時間目の体育館・・・

なんと!裸足で活動しているのは、中学部2年生・・・


【剣道の授業です。】


【元気いっぱい、お互いの竹刀を打ち合わせる生徒達・・・。】


【「蹲踞!(そんきょ!)お互いに礼!」・・・。礼儀作法もしっかり学んでいました。やはり日本の心「武道」はいいですね~!】
~つづく~
ココロを満タンに!(1/18)

【1月18日(火)朝、山に沈む満月・・・】

【大輪の花を咲かせている金盞花】
月に花に・・・。朝から感動をもらうことができました。そして、さらに今朝は・・・、

子ども達の心を満たしてくれる「朝の読み聞かせ」が行われました。



【絵本の世界に入り込んでいる子ども達】
今回読んでいただいた本は・・・(一部紹介します。)



表紙を見るだけでワクワクしてくる絵本ばかり。
読み聞かせボランティア「赤ずきん」様、読み聞かせ委員の皆様、今回も子ども達の心を耕し、栄養をたっぷり注いでいただきありがとうございました。
次回、2月15日(火)も楽しみにしています。
今日の給食&上学ニュース!(1/17)
〇コッペパン、牛乳
〇米粉のクリームスパゲティ
〇コールスローサラダ

くもり空の寒い1日でしたが、今日の給食は、パンに米粉のスパゲティと炭水化物祭り!
熱や力がわいてきました!


27年前の今日(1/17)、多くの犠牲を出した阪神淡路大震災が起こりました。
犠牲になった多くの方々のご冥福をお祈りいたします。
児童生徒会長が言うように、「自然災害はいつ起こるか分かりません」。昨日も、南半球のトンガで起こった大規模噴火に伴う津波が、日本にまで到達し、大変驚かされました。
今後も学校では、「自分の命は自分で守る」という合言葉のもと、子ども達の危険予測能力・回避能力を育成していきます。家庭でもこの機会に話し合ってみてはいかがでしょうか。
新聞掲載のお知らせ
おめでとうございます!
【お詫び】
以前ホームページで紹介した「新聞掲載のお知らせ~冬休み編~」に記載漏れ児童がいました。申し訳ありませんでした。紹介いたします。
〇 小学部5年、藤田 蓮さん「新春吹き出し大喜利」~特選~
おめでとうございます!
授業の様子②(1/14)

【6年生は、書き初めに挑戦中!】

【”感謝”の気持ちが字に表れていました!】

【5年生理科「もののとけかた」の学習です。】

【もの(砂糖や食塩などの個体)の溶け方にはきまりがあるのだろうか?】

【限界までとことん溶かしていきます。】

【大きなメスシリンダーを使って、ものが溶けていく様子を観察・・・。もわもわ・・っと溶けていく様子(シュリーレン現象)を感動しながら見つめていました。】
理科つながりで・・・

【中学部1年理科「光」の学習です。】

【子ども達が夢中で何かを眺めていますが・・・】

【ドラえもんのポケットから出したような不思議な望遠鏡で、景色を眺めてみると・・・】

【あ~ら不思議!!景色が上下反対になって映し出されました。なぜ、こんなふうに映し出されるのでしょうか?!その仕組は・・・】

【簡単に言うと、レンズによる光の屈折です。】
ここで、私の横に座っていた生徒のつぶやきに感動しました!
「先生が持っているカメラと同じ原理なんですね!」
その通り!!
以上、今週最後の授業の様子でした。また来週お目にかかりましょう!
Have a nice holiday!!

今日の給食&上学ニュース!(1/14)
〇麦ご飯、牛乳
〇れんこんつくね
〇ゆでもやし
〇豆乳みそ汁


豆乳のみそ汁です!しっかりと大豆の風味がして、おいしかったです。
【上学ニュース!】
今日は、図書館特集をお届けします。

【掲示物が、クリスマスバージョンからお正月のめでたい雰囲気に・・・】

【鏡餅に門松も・・・】


【かわいい雪だるままで。
 こんな素敵な雰囲気の図書館だから・・・】
こんな素敵な雰囲気の図書館だから・・・】
【貸出冊数の合計が、1万冊を突破!】
本好きの子ども達がたくさん育ってきています!

授業の様子①(1/14)
まずは1年生・・・、

【グループに分かれて鍵盤ハーモニカの練習】


【ほとんど間違えずに演奏できることにビックリ!音もしっかり出せるようになっていました。】

【4年生算数:CRTテストに向け、2学期までの学習内容を総復習中!】



【先生に採点してもらい、見事100点だったら・・・】

【カードにシールをはっていきます。みんな、「算数ばっちりで賞!」を目指し、意欲的に取り組んでいました。】

【中学部3年生体育:ボール運動(選択制)】


【ソフトテニスに・・・】


【サッカーに・・・】
残り少なくなった中学校体育の時間を全力で楽しんでいました。
~PART2へ続く~
素敵な贈り物・・・

手づくり絵本サークル「そらつくどん」様から、絵本のプレゼントです。

【手作りの絵本「元禄坊主踊り」:完成度の高さに驚かされます。】

*撮影時のみマスクを外しております。
「そらつくどん」様、ありがとうございました!
たくさんの子ども達が手に取って、目を輝かせながら読むことと思います。また、読み聞かせ等でも活用させていただきます。
学校便り「座論梅」1月号
授業の様子(1/13)
1月13日(木)、授業の様子です。

【5年生音楽。卒業式、修了式で歌う「校歌」の練習中です。】
理科室から楽しそうな声が聞こえてきたので行ってみると・・・

【小学部3年生理科。みんなで「生き物クイズ」にチャレンジしていました。】

【今年は寅年だけに、虎にちなんだ楽しい問題がずらり・・・。】
小学部1、2年生は、図工に夢中・・

【1年生は、正月らしくたこ作り。】

【マジックやクーピーを使って、たこの絵を表現。どんなたこが完成したのでしょうか?】

【大空に舞い上がる姿を早く見たいですね!!(来週「たこあげ大会」をするそうです。)】

【2年生「はさみのアート」制作中】

【画用紙をはさみでチョキチョキ・・・。】

【自由にチョキチョキ・・・。さぁ、どんなアートができたかな?】

【恐竜?怪獣???
 】
】
【カンガルー?オットセイ???
 上手にチョキチョキしましたね!】
上手にチョキチョキしましたね!】最後に中学部は、今日まで・・・


【実力テストに全集中!2日間お疲れ様でした~!】
今日の給食(1/13)
〇 麦ご飯、牛乳
〇 チキンチキンごぼう
〇 青パパイアスープ

早速ですが、なぞなぞです。
「お父さんが嫌いな果物な~んだ?」
・・・・・・・
もうお分かりですね!「パパイヤ(ア)」です!

今日は地産地消の日。新富町で作られている「青パパイア」を使ったスープが出ました。お恥ずかしながら「青パパイア」についてあまり知らなかったので、詳しくお伝えします。
パパイアは、30cmくらいの苗からすくすくと生長し、2~3m位の高さになると青いパパイアの実をつけるそうです。実を収穫せず、そのままにしておくと、ご存じ、黄色く甘いパパイアになります。
青いパパイアは、栄養たっぷりで今注目されている食材です。今日はスープですが、サラダにしたり、炒め物にしたり、どんな調理法でもおいしくいただけるそうです。
ちなみに、こちらはチキン好きにはたまらないネーミングの・・・

【チキンチキンごぼう!】(山口県の郷土料理だそうですよ!)
新聞掲載のお知らせ(1/12)
おめでとうございます!!
今日の給食&上学ニュース
〇マヨネーズパン、牛乳
〇白菜のクリーム煮
〇枝豆サラダ


【白菜のクリーム煮】
今が旬の白菜は、100年ほど前に中国から伝わった野菜だそうです。
今日の給食で使われている白菜は、新富町産です。寒い1日でしたが、体が温まりました。

【白菜畑をのぞき込む1年生・・・】

【上学白菜の旬は、もう少し先のようです。
 】
】【上学ニュース!】
5、6年生教室の前を通ると、子ども達が冬休み中に取り組んだ作品が、掲示されていました。

【5年生書き初め】

【力強い字ですねぇ~!】

【6年生:楽しかった冬休みの思い出が新聞にまとめられていました。】
担任の先生へ送った年賀状も展示中・・・。

SNSが普及し、年賀状離れが進んでいますが、やはり手書きは心がこもっていていいですね。

新聞掲載のお知らせ(冬休み中)
冬休み期間中も、たくさんの子ども達の作品が新聞に掲載されました。
おめでとうございます!
【作文の部】
〇 小学6年 早稲田 悠花 さん
(宮日こども新聞「新春こども作品」じゃーじゃー賞受賞)
題名「私の宝物」
〇 小学6年 澤村 健生さん
(宮日こども新聞「新春吹き出し大喜利」入選 1/8)
〇小学5年 黒木 裕翔さん
(宮日こども新聞「学園詩壇」掲載 12/25)
題名「あったかぽかぽか」
〇 小学6年 林田 煌太さん
(宮日こども新聞「新春こども文芸」掲載 1/8)
題名「新境地」
【短歌・俳句の部】
〇 小学6年 林田 煌太さん
(宮日こども新聞「新春こども文芸」掲載 1/8)
「書き初めでさらさら書いた今年の自分」
〇 小学5年 新惠 弘人さん
(宮日こども新聞「新春こども文芸」掲載 1/8)
「寒くなるねこもふとんでねています」
〇 小学5年 浮田 舞 さん
(宮日こども新聞「新春こども文芸」掲載 1/8)
「サンタさんみんなのためにプレゼント笑顔あふれる夢みたいだよ」
〇 小学6年 村田 優乃さん
(宮日こども新聞「新春こども文芸」掲載 1/8)
「初日の出宮崎の海コラボするみんなで見てお祭りみたい」
〇 小学6年 菅野虎太郎さん
(宮日こども新聞「新春こども文芸」掲載 1/8)
「初日の出真っ赤に染めた太陽がピカピカ光る幸せな色」
〇 小学5年 中武 旺雅さん
(宮日こども新聞「新春こども文芸」掲載 1/8)
「元旦に初日の出を見るきれいだないい1年になりますように」
〇 小学6年 矢野 輝 さん
(宮日こども新聞「新春こども文芸」掲載 1/8)
「年賀状みんな元気にしてるかな写真を見て心がほっとする」
【習字の部】
〇 小学5年 新惠 弘人さん(宮日新聞「みんなの作品」掲載 1/5)
〇 小学4年 黒木 悠斗さん(宮日新聞「みんなの作品」掲載 1/9)
【版画の部】
(宮日こども新聞「みんなの年賀状」、じゃーみー賞受賞 1/8)
〇 小学6年 澤村 健生 さん
(宮日新聞「2022迎春」掲載 1/3)
〇 小学6年 早稲田 悠花さん
1月11日(火)現在、新聞掲載者が、累計83名となり、今年度の目標であった80名を早くも突破しました。(昨年度42名)
今後も、子ども達の表現力育成を目指し、どんどん投稿を続けていきます!
新たな目標は、ど~んと100名掲載!です。
今日の給食(1/11)

今日から給食もスタートです!
【今日のメニュー】
〇麦ご飯、牛乳
〇ぶりの照り焼き
〇きゅうりの梅和え
〇雑煮


新年スタートにふさわしく「お雑煮」が出ました。昔から、お雑煮の餅には神様が宿るといわれています。
「今年も上学の子ども達全員、元気いっぱい過ごせますように・・・。
 」
」 3学期スタート!(1/11)
新年、明けましておめでとうございます。
今年も上新田学園をよろしくお願いいたします。

学校に、子ども達の元気な声が戻ってきました。
1月11日(火)、3学期のスタートです。3学期も、生き生きと学校生活を送る子ども達の様子を、ホームページにアップしていきたいと思います。(冬休み中に49万アクセスを突破しました!)今年も、度々お立ち寄りいただけたら幸いです。
まずは、始業式の様子からです。
新型コロナ感染症防止の観点から、校内放送に切り替えて実施しました。

【児童代表作文発表】
小学部2年生児童です。3学期に頑張りたいことは・・・
①読書、②CRTテストでよい結果を残すこと、③大きな声であいさつすること

【生徒代表作文発表】
中学部2年生の目標は・・・
①家庭学習を充実させる。②野球で地区大会優勝すること。③学級委員長として積極的な行動をとること。
上新田学園児童生徒諸君。今年は・・・

寅年です!(6年生、版画年賀状作品より)
様々なことにトライしていきましょう!

新聞掲載のお知らせ
おめでとうございます!
終業の日特集(よいお年を!)




【大掃除も終わり・・・(本当に無言で黙々と頑張る上学っ子達です!)】


【ドキドキの通知票も手渡され・・・。】

【中学部3年生は、2学期の感想を全員一言発表し・・・。いよいよ・・・】

【終業の日あるあるの、大きな荷物を持って、さようならです!】

【みなさん、よいお年を!また来年、元気に会いましょう!】
~終業の日特集「完」~
終業の日特集(中1Christmas Party)

中学部1年生が、何か楽しいパーティをするということで、急遽駆けつけました!
生徒も先生も大爆笑のパーティの様子をダイジェストでご覧ください。

【司会の4人組登場!あなたたちはいったい誰なの?
 】
】ここから様々な出し物が・・・

【ショートコントに・・・】

【ものまね???アイ ハブ アペン・・・】

【キレッキレのダンス。でも・・・】


【なぜか、みんな大爆笑!!】


【勇気を出して、パーティを盛り上げてくれてありがとう!こういうエンターテイナーが必要です!】
2学期最後に、とびっきり楽しい思い出ができましたね!
終業の日特集(学部集会)


【中学部学部集会の様子】
終業式の後の学部集会の様子です。
小学部は・・・

冬休みの過ごし方について、担当からの話です。

【今年を表す漢字一字は「金」です。「みんなにとって、今年頑張ったこと。自分へ金メダルを送りたいことは何ですか。冬休み中にしっかり振り返って、新たな目標を決めておきましょう。」】

【保健面の話】

【「早寝早起き」「三食しっかり食べる」「ゲームをしすぎない」「新型コロナ感染症防止の対策を引き続き行う」】
生徒指導部の話では・・・

【交通事故発生件数が1番多いのは・・・】


【12月です!「自転車の乗り方」「火遊び、エアガン禁止」・・・】
ルールを守って、思い出いっぱいの冬休みにしてくださいね!
~次回「大爆笑!中1お楽しみ会!」をお届けします。~
2学期終業式

終業の日特集。まずは、終業式の様子からです。


【児童生徒代表作文発表「2学期を振り返って」:全体に伝わる声で、堂々と発表できました!】

【校長先生の話:冬休みも、新型コロナウイルス感染予防の徹底と、「上学宣言」を意識して生活して欲しい。】


【校歌斉唱~小学部~】


【中学部】
子ども達は、儀式の意味を十分理解し、立派な態度で臨むことができました。
~終業の日特集 つづく~
今日の給食&上学ニュース!(12/24)
〇麦ご飯、牛乳
〇中華うま煮
〇千切り大根の酢の物

明日から冬休み。今日が2学期最後の給食です。
冬休みも、好き嫌いせず、三食しっかり食べて、健康な毎日を過ごしていきましょう。

【2学期最後の給食も・・・】

【おししかったで酢!】
【上学ニュース!】

【毎朝、子ども達への温かいメッセージが書かれている小学部3年生黒板より・・・】
12月24日(金)、いよいよ2学期終業の日です!
まずは・・・。

暑い日も、寒い日も、雨の日も、風の強い日も、毎日、子ども達の安全を見守っていただき、ありがとうございました。



3学期も、どうぞよろしくお願いいたします。
それでは、この後、上学終業の日の様子を特集でお伝えしていきます。
お楽しみに!!
学期末あるある・・(12/23)
学期末と言えば・・・、今回は、「学期末あるある!」をお届けします。

1年生は、2学期取り組んだたくさんの作品を家庭に持ち帰る準備中・・・

【思い出の作品ばかりだね!】

【準備完了!早く終わったからと言って・・・】

【持ち帰り用バッグで遊んじゃ~ダメ!ダメ!
 】
】5、6年生は、学期末あるあるの・・・

【お楽しみ会!6年生は・・・】

【男子VS女子で・・・】

【陣取り??早くお宝をゲットした方が勝ちみたいです。ルールはよく分かりませんが、みんな楽しそう!楽しすぎて・・・】

【坂道ダ~イブ!服が芝生と泥だらけに・・・。担任「家に帰ったら、自分で洗濯しなさいよ!」
 (当然!)】」
(当然!)】」5年生はというと・・・

【ベースボール中!】

【バットをラケットに持ち替えて・・・。「パコ~~ン!」かっ飛ばしていました。】
4年生は・・・

【本日の「お楽しみ会」の準備中・・・。準備も楽しい時間ですよね!】

【何を作っているのかな?】


【景品作りに励んでいました・・・】
小学部「学期末あるある」~おしまい!~
いよいよ明日、2学期終業の日です!!
今日の給食~Merry Christmas~
〇コーンご飯、牛乳
〇煮込みハンバーグ、ブロッコリー
〇オニオンスープ
〇クリスマスデザート

今日のデザートは、なんと・・・

【クリスマスケーキ!このかわいいサンタの絵を見ただけで、子ども達はニコニコ顔に・・・。
 しかも、セレクトケーキです!】
しかも、セレクトケーキです!】私が選んだのは・・・・

【ロールケーキ!(フワッフワッの生クリームがとてもおいしかったです!)】
↓僕が選んだのは・・・

【チョコレートケーキだよ!】

【小学生は断然チョコケーキが人気でした!】
さらに・・・

【うれしくて、職員室まで私を呼びに来た少年です。何がそんなにうれしいのかというと・・・
 】
】
【ラッキースターにんじんが入っていたのです!
 】
】さらに・・・声をかけられ、4年生教室に入ってみてびっくり!なんと・・・

【ダブルラッキースター!!
 この幸運を手に入れたのは!?】
この幸運を手に入れたのは!?】
【わたしです!!きっと何かいいことがあるでしょう!(最後まで残しているところがかわいいですね!)さぁ、2個まとめて召し上がれ!
 】
】 切磋琢磨⑩(中学部2年音楽)

2学期最後の相互参観授業「切磋琢磨」です。
中学部2年音楽「平調子の特徴を生かして音楽をつくろう(創作)」の学習です。

【箏で音楽を創作するみたいです・・・。すごい!】



【「ターターターー!」まずは、タブレットを使い、リズムを作っていきます!】
その後

【リズムと音を組み合わせていきます。もう夢中です!】
そして、最後に・・・

【発表会。静まり返った音楽室に、美しい箏の音色が響きます。】

【響きます・・・。あ~、癒やされる・・・】
和の心を育むと共に、創作することの喜びを感じることのできた生徒達でした。
切磋琢磨⑨(中学部1年英語)

続いては、中学部1年英語を参観させていただきました。

【まずは、英語のウォーミングアップ!】

【BGM流れる中・・・】

【楽しくスキルアップ!】
そして、今日の学習内容へ・・・
めあては、「相手に今何をしているか尋ねるにはどうしたらいいのだろう。」現在進行形の学習です。


【例文で現在進行形の表現に慣れた後・・、とにかく実践です!まずは・・・】

【タブレットの電話機能を使って、音声で理解できるか確認。さらに・・・】


【チャット機能を使い、メール交換。もちろんEnglishで!】
スモールステップで生徒を飽きさせず、さらに、非常にテンポのある授業で、50分という時間があっという間に過ぎていきました。

子ども達のこの笑顔が、楽しかった1時間を物語っています。

アダム先生も楽しそう・・・

切磋琢磨⑧(中学部2年社会)

教師一人一人の授業力向上を目指し取り組んでいる、相互参観授業「切磋琢磨」PART8、中学部2年社会「中部地方」の授業の様子です。

めあて「中部地方の農業や工業にはどのような特色があるのだろうか」


【まずは、一人で調べてみよう!タブレットに送られてきた資料から特色を考えていきます。】


【グループでの話合い】

【お客さんなっている生徒は一人もいません!一人一人が意欲的に話合いに関わっている姿が素晴らしいと思いました。】
今回の社会科の授業では、生徒が主体的に取り組んでいる姿が印象的でした。タブレットを効果的に活用したこともあるのでしょうが、日頃の授業の積み重ねの成果だなと感じました。
今日の給食&上学ニュース!(12/22)

【児童生徒会長の一言より】
ということで・・・
今日の給食には、

かぼちゃのポタージュが出ました。
今日は、給食で栄養のあるかぼちゃを食べ、ゆず風呂でゆっくり(これは願望・・
 )したいと思います。
)したいと思います。【今日のメニュー】
〇米粉パン、牛乳
〇かぼちゃのポタージュ
〇アーモンド和え

【アーモンド和えも食感がコリコリしていておいしかったです!】
【上学ニュース】
21日(火)、中学部クラスマッチの様子です。

【アジャタ対決に・・】


【ドッジボール・・・】
結果は・・・

さすが!中学部3年生がダブル優勝を果たしました!!
持久走大会特集③【レースを終えて・・】
レースを終えて・・・


【完全燃焼!!力尽きる生徒達・・・。この姿にも感動です!】
小学部では・・・

【好成績を残した子ども達が最高の笑顔を見せてくれました。】

【金メダルのガッツポーズ!】

児童代表の言葉
「みなさん目標に向かってよく頑張りました。(中略)この経験をこれからの生活に生かしていきましょう!」

保護者の皆様の応援のおかげで、子ども達一人一人がパワーアップし、光り輝いた大会となりました。
年末のお忙しい中、来校いただき、誠にありがとうございました!
(次回は、今年度最後の参観日です。2月17日(木)を予定しています。)
~「持久走大会」特集FIN~
持久走大会特集②(小学部編)


持久走大会小学部編です!中学部に引き続き、たくさんの保護者の方が注目する中・・・。
まずは、3、4年生からです。位置について・・・

【緊張気味の子ども達・・・。】

【一斉にスタート!自己ベスト目指し、心を燃やせ!】

【運動場2周走った後、1周600mの外周コースへ・・・】

【苦しい表情の中にも、充実感あふれる表情でゴールしています。】
続いて・・、元気はつらつ1、2年生のスタートです!

【先生「がんばるぞ~!」→子ども「オ~~~!」先生「転んでも泣くな~!」→子ども「お~~~~!」
 】
】
【小学部1、2年生あるあるのロケットスタート!】
運動場を4周(800m)します。

【ゴ~~~ル!最後まで全力で走りきる姿に感動・・・。
 】
】最後に、小学部のトリを飾るのは、もちろん5、6年生。注目のレースです!

【円陣を組み、リーダーO君「自分の目標を達成するぞ~」5、6年生「お~~~!」】

【運動場3周、外周1周の1200m。自己ベスト目指し一斉にスタート!】

【全力で走る姿は、みんなかっこいいです!
 】
】
【勝負は、いつも練習で競り合っていた2人のラストスパート対決へ・・・】

【男子の部優勝!!】

【女子の部優勝!その後も続々と・・・】

【全力でゴールを走り抜ける子ども達。感動の走りをありがとう!】
~次回「レースを終えて・・・」(番外編)をお届けします。~
持久走大会特集(中学部編)
まずは、中学部から・・・


【男子の部(3km)、女子の部(2km)スタート!】


【まずは、下り坂。スピード全開です!行きはよいよい、帰りは・・・
 】
】
折り返し後、いよいよ上学持久走大会恒例の「心臓破りの坂」へ・・・



【この上り坂はきつい・・・
 がんばれ~~!】
がんばれ~~!】さぁ、レースの行方は!?最初に運動場に姿を見せたのは・・・

【中学部3年生の2人です!】

【デッドヒートの結果は・・・】(全ての結果は、「学校便り」でタイムとともにお知らせします。)

【表彰式。男女8位までに賞状が送られました。】
~つづく(次回小学部編へ)~
今日の給食&上学ニュース!(12/21)

持久走大会、皆さんお疲れ様でした!(子ども達の感動の走りは、後ほど・・・)
さぞお腹がすいたことでしょう!?
まずは、今日の給食からです。
【今日のメニュー】
〇麦ご飯、牛乳
〇宮崎牛のすき焼き煮
〇紅白なます

今日は、持久走頑張ったご褒美でしょうか、宮崎牛のすき焼きが出ました!

【宮崎牛、だ~~いすきやき!
 】
】【上学ニュース!】

小学部4年生の教室です!
小学4年生と言えば・・・、座論梅の梅シリーズ、梅干し、梅ジュースに引き続き第3弾・・・

THE 梅ゼリー!!

【あっま~~~い!】

学級懇談会の後、保護者にも・・・

【「いつもありがとう!」のメッセージとともに・・・】

【ちょっと早めのクリスマスプレゼントです!
 】
】 今日の給食&上学ニュース!(12/20)
〇減量コッペパン、牛乳
〇ナポリタンスパゲティ
〇ひよこ豆のサラダ

カルシウムやタンパク質が豊富に含まれている「ひよこ豆のサラダ」が出ました。

【ひよこ豆・・・、名前もかわいいですね!
 】
】【上学ニュース!】

12月17日(金)、今年度、本校が取り組んできた「人権の花運動」。この取組に対して感謝状をいただく、贈呈式が行われました。

【主催者代表あいさつ】

【感謝状贈呈】


【児童生徒代表お礼の言葉】

この1年間の「人権の花運動」への取組により、生命を大切に思う気持ちや責任感が育ち、子ども達の心にも花を咲かせることができたと思います。
この運動をサポートしてくださった関係機関の皆様、誠にありがとうございました。
切磋琢磨⑦(中学部1年国語)

中学部1年国語「いにしえの心にふれる」の授業の様子です。
めあて「漢文(訓読文)はどのようなきまりに従って読んでいけばいいだろうか」
まずは、前時の振り返り・・・

【「矛盾」とはどんな内容だったかな?】

【ペアで説明し合います。前時の学習内容をしっかり理解していることが伝わってきました。】

【返り点の決まりについて、教師が丁寧に指導していきます。その後・・・】

【問題に挑戦!】


【自力解決の後、小グループで確認。みんな意欲的ですね!】


【発表タイム!】
漢文のきまりを理解することで、いにしえの心にふれることができた生徒達でした。
*私自身、レ点、一二点など、むか~~し学んだことがよみがえってきて、とても楽しい時間でした!

切磋琢磨⑥(小学部1年算数)

切磋琢磨シリーズ、PART6。
1年生算数「ものとひとのかず」の授業の様子です。めあては・・・

【「どんなずをかけば、なんにんになるのかを、もとめることができるのだろうか」です。】
まずは、1年生のノートの字が、みんな上手なのにびっくりです!

【聞く姿勢、書く姿勢もすばらしい!】
とても難しい内容でしたが、分からないときは・・・

【先生が集めて、ヒントを出していきます。】

【何とか解けないか、自力で頑張る子ども達・・・】

【図をかいて自分の頭の中を整理。ずいぶん分かりやすくなりました。】

【自分のノートを写真に撮って提出!】

【全体で発表。説明も大変よくできました!

【説明を聞く子ども達。目が一点に集中できています。】
子ども達の学習態度の素晴らしさ、主体的に取り組む姿勢、先生の分かりやすい説明どれも、大変参考になる授業でした。
授業後、1年生の頑張りに、先生達から大きな拍手が送られました。
「パチパチパチ・・・」
今日の給食&上学ニュース!(12/17)
〇麦ご飯、牛乳
〇さばゆずみそ煮
〇のっぺい汁


さばのゆずみそ煮、ほんのりゆず味で季節を感じることができました。
【上学ニュース!~あいさつ名人発表の巻~】
お昼の放送では、現在・・・


【小学部あいさつ名人放送中!】
以下の人たちが、今回選ばれた児童です。
〇林田 詩葉さん(小1)
〇山本 涼羽さん(小2)
〇淵脇 愛輝さん(小3)
〇德井 美咲さん(小4)
〇中武 旺雅さん(小5)
〇黒木 宏崇さん(小6)
これからも明るい声を響かせ、みんなを元気にしていってくださいね!
小さな旅⑰(12/17)
まずは小学部2年生から・・・

【サンタさんだ~~!
 図工で作ったようです!他にも・・・】
図工で作ったようです!他にも・・・】
【THE モンスター!!
 制作者はかくれんぼ!?】
制作者はかくれんぼ!?】
【み~つっけた!】


【ベンチでくつろぐ仲良し3人組。かわいいねぇ~
続いて、小学部3、4年生・・

【ニコニコ笑顔で、何かをおいしそうに飲んでいる小学部3年生】

【ジャ~~ン!】
「座論梅の梅」シリーズ、前回の梅干しに続き今回は、正反対、あま~い梅ジュース!

【心優しき4年生が、3年生へお裾分けです!炭酸で割っていただきます!】

【グッジョブ!】

【4年生:おいしいジュースに生まれ変わって、私たちもうれしいです!!】
まだまだ続きます。
5年生は・・・

「お米学習」の最終章、しめ縄作りです。

【ねじねじねじ・・・。職人技を見せる子ども発見。いい仕事してますねぇ。】

【正月、玄関に飾るのかな?】

【来年もいい年でありますように・・・】
最後に中学生は・・・

【玉入れ?来年の運動会の練習?

【失礼しました!「アジャタ」という競技玉入れでした!
 】
】
【何事も積み重ねが大事・・・。そんなにたくさん投げられる?
 】
】
【そ~れっ!とんでいけ~~!】

【ナイスシュート!】
21日(火)にこの競技のクラスマッチをするそうです!
チームワークが勝負の鍵ですね!白熱の試合をまたお届けしたいと思います。
~小さな旅⑰「おしまい!」また来週お会いしましょう!
 ~
~ 今日の給食&小さな旅⑯(12/16)
〇麦ご飯、牛乳
〇白菜のあんかけ丼
〇ひじきの油炒め

37.17%
これは、何の数字だと思いますか?
実は、過去最低を記録した、「日本の食料自給率」です。1日の食事のうち1食分しかないのです。
毎月16日は、「ひむか地産地消の日」です。新富町では、たくさんの野菜や果物、米や肉、卵などが作られています。給食だけでなく、もっともっと安心、安全な地元の食材を食べたいと思います!
【小さな旅⑯】

オレンジ色の太陽が、まさにドラゴンボールのように見えた、今朝の美しい朝焼けです。しかし、昔からきれいな朝焼けが見られた日は、その後・・・

やはり雨が降ってきました・・
では、昨日の続きです。冷たい雨を癒してくれる、心温まる上学の風景をお伝えします。

【人権の花に水やりをしてくれていた中学生。毎朝ありがとう!】

【こちらも水やり中・・・。何を植えたのかな?】

【ねぇ、何を植えたのかな?】


【子ども達は、「あねのね」と言っていましたが、「アネモネ」ですね!
 】
】
【英検合格に向け、朝から指導を仰ぐ中学部3年生】

【ねぇ、何を数えているのかな?】

【収穫したピーマンをうれしそうに数えていました・・・癒やされる
 】
】~おしまい!~
5年生からの挑戦状!!

1学期、中学2年生から3年生へ、届けられた校歌対決の挑戦状・・・
学年をまたいで切磋琢磨していこうとするこの伝統は・・・、

【小学部にも受け継がれています!】

小学5年生から6年生への挑戦状です!何を挑むのかというと・・・

長縄8の字跳びです!
決戦の様子をお伝えします!


お互い円陣を組み、気合いを入れます!
3分間でどちらが多く跳べるのか!
よ~~い!スタート!!

【5年生:スピードはありませんが、ひっかからないように、順調に数を伸ばします・・】

【6年生:すごいスピード!しかし、ミスも・・・】
結果発表!WINNER・・・

【5年生チーム!!】
敗者6年生は、上小恒例の・・・

【さわやかに・・・、「ざんね~~ん!」
 】
】今回は、5年生に軍配が上がりましたが、その日の昼休み、子ども達同士で声を掛け合い、一生懸命練習している6年生の姿が見られました。
学年1クラスの上新田学園。学年をまたいで1つの目標に向かって、切磋琢磨する姿は、とてもいい光景でした。
次の対決も楽しみにしています!
地域の皆様へ(12/16)

いつも上新田学園を応援していただいている地域の皆様。日頃より本校の教育活動へのご理解、ご協力をいただき、誠にありがとうございます。
さて、地区への回覧を使ってお伝えしていた、持久走大会が来週火曜日(12/21)と近づいてきました。
当日はぜひ、お時間の許される範囲で、温かいご声援をいただけると、子ども達がさらに頑張ると思います。よろしくお願いいたします。
詳しい計画等は、下の文書をご覧ください。
R03上新田地区回覧用文書.pdf
持久走大会コース.pdf
今日の給食&小さな旅⑮(12/15))
〇セルフドッグパン、牛乳
〇ソーセージ、キャベツ
〇野菜スープ

今日の給食はホットドッグです。ご存じのように、その形がダックスフンドによく似ていることから名前が付けられました。
では、アメリカンスタイルで・・・

【かぶりつきでいただきます!】
【小さな旅⑮】
ここ2日間は、流れ星の話題で持ちきりです。
三大流星群の一つ、双子座流星群がピークを迎えていましたね!数は減りますが、まだ2、3日は見られるそうです。厚着をして、家族で眺めてみるのもいいですね!
ちなみに、中学部理科の先生は、6個くらい見たそうです!私は、朝方1個だけでしたが、感動しました!
それでは、ここ最近の上学のちょっとした心温まる風景をお届けします。
まずは、図書館から・・・

【Christmasバージョンにリニューアル!】



【ワクワクする掲示物に大喜びの少年!】

【冬でも色とりどりの花が出迎えてくれる我が校の玄関にも・・・】

【クリスマスが訪れました!ポインセチアです。】
最後に、クリスマスからは離れてますが、持久走練習前のひととき・・・

【小学部6年生女子。BTSのダンスを踊り、リラックスムード。一方男子は・・・】

【そーれ!1、2、3・・・。楽しそうに「ガニガニ体操」。足をもっと上げて~!
 。】
。】*実は、NHKでも紹介された運動効果抜群の体操なんですよ!】
~つづく(また明日お会いしましょう!)~
学校便り「座論梅」12月号発行
ココロを満タンに!

12月14日(火)、心に栄養を注いでくれる「読み聞かせ」が行われました。


【楽しい絵本の読み聞かせに・・・】


【笑顔の子ども達・・・】
中学部では・・・

【二人同時で読み聞かせ???】

【夢のコラボ!英語と日本語で読み聞かせ!左(英語の先生)、右(ボランティア「赤ずきん」の方)】
今日読んでいただいた本は・・・(一部ですが)



今日も、子ども達の心を耕し、心に栄養をたっぷり注いでいただきました。心が満タンになりました!(ごちそうさまでした!
 )
) 今日の給食&上学ニュース!(12/14)
〇麦ご飯、牛乳
〇炒り鶏
〇三色ナムル

給食で使っているもやしは、ブラックマッペという豆から伸びたものだそうです。他にも、緑豆や大豆から芽を出すもやしもありますね。スーパーでもやしを見かけたら、どの豆から出てきたものか見てみるといいですね!

【シャキッシャキの歯ごたえ!おいしくいただきました!】
【上学ニュース】
家庭科室から楽しそうな声がしたのでのぞいてみると・・・

5年生が、「お米学習」の一貫として、おにぎりをつくっていました。

【具は何を入れているのかな???】

【梅干しに・・・】

【全ての具材を入れて、デラックスおにぎりを作っていた少年】

【愛情込めて、にぎにぎします!】

【かんせ~い!
 彼曰く「なんじゃこりゃおにぎり」だそうです!その他にも・・】
彼曰く「なんじゃこりゃおにぎり」だそうです!その他にも・・】
【あららっ、かわいい!?アイデア賞!】
では・・・

【実食です!自分でにぎったおにぎりの味は???】

【この表情が物語ってくれています!
 】
】~番外編~

【私にもお裾分けしてくれました!ありがとう~!
 】
】 切磋琢磨⑤(相互参観授業)

教師が互いの授業を参観し、評価し合う中で、授業力向上を図っていく、相互参観授業「切磋琢磨」シリーズ、PART5です。
中学部3年数学「三平方の定理」の授業の様子です。


学習問題「直角三角形の辺には、どんな特徴があるのだろうか?」
いわゆるピタゴラスの定理を導き出す学習です。

【難しい問題ですねぇ・・・。でも、何とか自力解決を目指す姿勢はさすが中学3年生です!】
そして、困ったときは・・・


【仲間が助けてくれます。】

【先生も分かりやすいヒントをくれます。】
そして、ついに・・・

生徒達の力で、導き出すことができました。(ピタゴラスに近づけましたね!
 )
)最後に・・・

【授業の感想等をタブレットに入力し提出】
月曜日の1時間目という、あまりテンションの上がらない時間ですが、生徒達は、教師の話をしっかりと聞き、反応し、発言し、理解していました。
主体的に取り組む姿が素晴らしいと感じた授業でした。
作文がラジオから流れます!
MRTラジオ「私たちの作文」コーナーです。
〇 放送日:12月17日(金) 16:50~
〇 題名「ぼくの考える夢のロボット」
おめでとうございます!!
今日の給食&上学ニュース!(12/13)

【朝の保健室前・・・】

【子ども達が眺める先にあるものは・・・】


【手洗い、消毒を啓発するために、保体給食委員会が行った実験のようです。】
【ビフォー:トイレの後手洗いなし。ばい菌だらけです!
 手洗い+消毒をした実験では・・・】
手洗い+消毒をした実験では・・・】
【アフター:なんということでしょう!

【給食前、いつもよりていねいに手洗いをする子ども達でした。】
では、清潔になった手で、気持ちよく今日の給食へ!!
【今日のメニュー】
〇減量コッペパン、牛乳
〇五目焼きそば
〇蒸しギョーザ

今日の給食には、宮崎市が消費量日本一を目指しているギョーザが出ました。
中国語の正しい発音は、ジャオズだそうです。

みなさんは、焼きギョーザ、水ギョーザ、揚げギョーザ、蒸しギョーザ、どれが好きですか?

【上学ニュース!「持久走大会試走」~中学部編~】
前回の小学部に引き続き、持久走大会試走、今回は中学部編です。
中学部は、男子3km、女子2km・・・。

【ロケットスタートを決めようと構える中3コンビ・・・】

【スタートダッシュ!と思いきや・・・。今回は、コースを確かめるために、全員ゆっくり走るようです。
 】
】
【そして、校外へと・・・。ランランラン♪】

【折り返します!がんばれ~~!】

【上中持久走大会伝統、最後の「心臓破りの坂」を登り切りゴ~~ル!】
これから、体育、部活、自主練を通して、この坂を全力で走りきる持久力をつけていきましょう!!
* ちなみに、数十年前の上中持久走大会は、男子8km、女子4kmでした。
週末の上学ニュース
○ 小学部6年生、村田優乃さん(宮日こども新聞「学園俳壇」掲載 12/11)
「秋の記号ひらひらと落ちるイチョウの葉」
○ 小学部6年生、林田煌太さん(宮日新聞「若い目」掲載 12/11)
題名「最近のニュース」
○ 小学部6年生、早稲田悠花さん(宮日新聞「若い目」掲載 12/12)
題名「最後の体育大会」
* 今年度新聞掲載者累計67名
【48万アクセス突破!】
本校ホームページのアクセス数が、12月11日(土)に48万アクセスを突破しました。
毎日たくさんの方にお立ち寄りいただき、大変うれしく思っています。
今年度初めに立てた大きな目標50万アクセス目指し、今後も日々更新を続けていきますので、度々お立ち寄りいただけたら幸いです。
今日の給食&上学ニュース!(12/10)
〇麦ご飯、牛乳
〇おでん煮
〇ごま酢和え

おでんのおいしい季節になりました。おでんも地域によって具材が違っていたり、味付けが醤油だったり、味噌だったりするそうです。
今日の給食は、おでん風にアレンジした煮物でした!

【よく味がしみていて、おいしかったです!
 】
】【上学ニュース!】

12月10日(金)、3校時、小学部は、運動会以来の全校体育です。
持久走大会に向けての試走です。
低学年800m、中学年1000m、高学年1200m、3~6年生は、運動場と外回りを走ります。

【やる気みなぎるロケットスタート!!でも、大丈夫?!】

【がんばれ~!】


【がんばれ~~~!】

【がんばれ~~~~~~~~~~!!】
さすが上学っ子!途中であきらめたり、歩いたりする子が一人もいなかったことにビックリです。
みんなよくがんばりました!きっと持久走大会では、感動の走りを見せてくれることでしょう!


【この姿が全力で走ったことを物語っています。おつかれさま・・・
 】
】 いざ!全国の舞台へ!
中学部3年生の緒方愛莉さんと黒木アースリーさんです。
県の代表として、全力でプレーしてきてください!
活躍を祈っています!
しんとみ発見学びフロンティア塾生来校
「しんとみ発見学びフロンティア塾」とは、新富町の文化や歴史、教育等について主体的に学ぶ中で、新富町のよさを再発見することを目指す教室です。
今回は、本校の教育活動の取組や子ども達の様子を見てもらいました。

【学校経営等の説明】


【中学部授業の様子.。一人一台タブレットに驚かれていました。】

【小学部:図工の学習】


【いろいろアドバイスしていただきました。】

【たくさんの目が注がれ、ドキドキの3年生・・・
 】
】
【小6音楽「箏」の学習】

【小学生の奏でる箏の音色・・・、塾生のみなさんにも喜んでいただきました!
 】
】たくさんの方に来校いただき、子ども達もうれしかったようです。
ありがとうございました。ぜひ、またお越しください。
今日の給食&上学ニュース!(12/9)
〇麦ご飯、牛乳
〇ビビンバ丼
〇わかめスープ

今日は、本校中学部3年生のリクエスト献立です!
中学3年生の人気メニューは、「ビビンバ丼」「カレーライス」「チキン南蛮」「ツナサラダ」「ブロッコリーサラダ」「みそ汁」だそうです。
中学3年生、今頃、大好物のビビンバ丼を、おいしそうに食べていることでしょう!



【上学ニュース!】
Christmasコンサートの後、表彰を行いました。

【少年野球チーム:優勝旗後納】

【町ポップカードコンテスト、最優秀賞、優秀賞表彰】

【県読書感想文コンクール入選】

【動物画コンクール入選】

【防犯・防災標語コンクール金賞】
おめでとうございます!
3学期もたくさん表彰されるように頑張りましょう!
Christmas Concert in Kamigaku

12月9日(木)、上新田学園が一気にクリスマスムードに・・・。
ハンドベルクラブ、「クリスマスコンサート」の様子をお届けします。

【クリスマスメドレー、まずは、「Silent Night! Holy Night! ♪」

【Mickey Mouse March ♪】


【We Wish You a Merry Christmas ♪&ジングルベル♪】
聞いている子ども達は・・・


【いい音色だなぁ~~
 】
】保護者の方々も・・・

【うっとり・・・
 】
】ハンドベルクラブの皆さん、今回も素敵なひとときをありがとうございました!

【Merry Christmas!!(ハンドベルクラブ6年生のみなさん)】
今日の給食&上学ニュース!(12/8)
〇黒糖パン、牛乳
〇キャロットシチュー
〇ツナサラダ

今日は、キャロットシチューが出ました。宮崎県でとれたにんじんをすりつぶして裏ごしした「ピューレ」を使ったそうです。

【おしゃれなオレンジ色ですね!(〇〇先生は、「明太子スープ?」と言っていましたが・・・
 】
】【上学ニュース!】

中学部2年調理実習の様子です!さぁ、何を作るのでしょうか!?
食材は・・・

【これです!!では、Let's Cooking!】


【玉ねぎを刻んで・・・
 】
】



【もうお分かりですね!
 】
】
【ミートソーススパゲティです!!】
それでは、みんなで・・・


【いただきま~す!
 最高の笑顔ですねぇ~】
最高の笑顔ですねぇ~】ここで終わりではなく・・・

【片付けまでがお料理!協力してしっかり取り組む中学生!さすがです!】
新聞掲載のお知らせ(12/8)
おめでとうございます!!
理科は感動だ!⑪

日が暮れるのが本当に早くなってきましたね。
昨日、18:00には、南西の空に三日月と金星が仲良く輝いていました。
全くの偶然ですが・・・

本日、中学部3年生は、「月の満ち欠け」を勉強をしていました。
ということで・・・
理科は感動!PART11をお届けしていきます。

【先生「昨日の三日月と金星を見た人??」生徒「は~~~~い!!」(観察してくることが宿題だったようですね・・
 )】
)】ここで問題・・

【時間と満ち欠け、方角を答える難問】
(例)上弦の月は、( )頃( )の空に見え、( )頃( )の空に沈む。(正解は最後で・・・)

【さぁ、中学3年生!目指せ全問正解!】


【「三人寄れば文殊の知恵・・・」ただ今、相談中】

【解説中!わかりやす~~い!】
普段何気なく見上げる月や星ですが、理科で知識をインプットすると、また違った見方で自然を眺めることができます。やはり、「理科は感動ですね!」
〔正解〕上弦の月は、日暮れ頃、南の空に現れ、真夜中頃、西の空に沈む。
続いては・・・

小学部5年生「振り子のきまり」の続きです。さぁ、ガリレオ・ガリレイが発見した「規則性」を発見することができたのでしょうか!?
学習問題「振れ幅を変えると、振り子が1往復する時間は変わるのだろうか?」

【振り子の重さ、長さの条件をそろえて、振れ幅だけを変えて実験します。】

【「1、2、3・・・」10往復の時間を3回計測し、1往復の時間の平均を出していきます。】

【誤差が最小限になるように、慎重に実験、計算を繰り返していました。】
結論・・

【「振れ幅を変えても振り子が一往復する時間は変わらない!」】
ということは・・・、
最終結論!(ガリレオが発見した規則性は)
「振り子が1往復する時間は、振り子の長さを変えたときのみ変わる。」
ガリレオに一歩近づき、喜ぶ5年生。早速・・・

【昼休みブランコに乗って遊んでいました!
 振り子の規則性を理解した後です。また違った乗り心地を味わっていることでしょう!】
振り子の規則性を理解した後です。また違った乗り心地を味わっていることでしょう!】~理科は感動だ!⑪「おしまい!」~
切磋琢磨④(12/7)

教師一人一人の授業力向上を目指す相互参観授業、「切磋琢磨」特集、PART4です。
小学部4年生国語物語文「プラタナスの木」の授業です。

主人公(マーちん)のプラタナスの木に対する気持ちの変化について読み取っていきます。

【まずは、本文から、気持ちの変化のきっかけとなった部分にサイドラインを引いていき、それに対する自分の考えを・・・】



【タブレットに入力。その後・・・】


【グループでの話合いです。「教科書の〇〇ページに~と書いてあるので、~と思います。」】
そして・・・

【全体で共有していきました。】
今回の授業では、叙述に即した深い読み取りからの発言も多く見られ、速く正確に読み取る力が育っているなぁと感じました。
~切磋琢磨⑤へ続く~
今日の給食(12/7)&授業の様子SP
〇麦ご飯、牛乳
〇メンチカツ、キャベツのレモン和え
〇じとっこ汁

今日のじとっこ汁には、宮崎県産の「地頭鶏」が使われていました。普通の鶏肉よりも旨味が強いので、だしが出てとてもおいしかったです。

【野菜もたっぷり(コラーゲンも!)入っていて栄養満点でした!】
【授業の様子】
子ども達が、生き生きと取り組んでいた授業の一場面を紹介していきます。

【ただ今、縄跳び二重跳びに挑戦中!】

【ドキドキのリコーダーテスト!】

【たきぎ拾い?】

【図工の工作で使うのだそうです!どんな作品ができるのでしょう!?楽しみです!】

【小学部5年生、「振り子の規則性」を実験中・・。(詳しくは、また次回の「理科は感動だ!」でお届けします。)】
中学部2年生は・・・

【箏に挑戦中!】


【音をお聞かせできないのが残念です!
 】
】最後は、生き生きとというよりも・・・


【小学部5年生と中学部2年生が、全力で取り組んだ「みやざき学力学習状況調査」】
~おしまい!~
切磋琢磨③(「理科は感動だ!」の巻)

相互参観授業「切磋琢磨」もPART3となりました。

【前回の「理科は感動だ!」の小学部3年生同様、鏡を使う学習のようですね!】

中学部1年生理科「光による現象」です。
学習問題「全身を映すために必要な鏡の大きさはどうなるだろう」
この学習問題を解決するために協力していただいたのが、この人!!

【おとみちゃんです!】
身長28cmのおとみちゃん(キャラクター)が、自分の全身を鏡に映すには、縦何cmの鏡が必要だろう?
みなさんも一緒に予想してみてください。

【ア 28cm以上 イ 28cmぐらい ウ 21cmぐらい エ 14cmぐらい オ 7cmぐらい】

【自分の予想をタブレットを使って提出。】
この問題提示で、生徒の知的好奇心に火がつきました!
意欲的に実験に取り組む生徒の様子をご覧ください。

【おとみちゃん目線で実験していきます。】

【頭から、足までは、何cmかな???】

【離れて見ると映るんじゃないだろうか???】
試行錯誤を繰り返した結果、正解は・・・

【エの14cmです。おとみちゃんの身長の半分の大きさが必要なんですね!感動!!】
まとめ「全身を映すために必要な鏡の大きさは、身長の半分になる。」
今回の授業では、問題におとみちゃんを登場させたことで、ぐっと身近なテーマになり、生徒の主体的な学びへとつながりました。理科以外の教科でも、大変参考になる授業でした。
~次回、相互参観授業「切磋琢磨」④は、小学部4年生国語の授業の様子をお届けします。~
今日の給食&上学ギャラリー!(12/6)

「今日の給食!!」
ではありません・・・


上学ギャラリー、1年生の作品「ごちそうパーティーへようこそ!」です。


【おいしそう・・・。でも、こんなに食べられる?!】



【1年生の作品とは思えない、このクオリティの高さにビックリです!
 】
】では・・・、

【いただきま~す!①】

お待たせしました!本物の給食です・・・。
【今日のメニュー】
〇減量コッペパン、牛乳
〇カレーうどん
〇カラフルピーマン炒め
今日は、カレーうどん。カレーライスとはまた違い、出汁がきいていてとてもおいしかったです。では・・・

【いただきま~す!②(ワイシャツに汁がつかないように気を付けて食べま~す!
 )】
)】 新聞掲載のお知らせ(12/5)
おめでとうございます!
新聞掲載のお知らせ(12/4)
おめでとうございます!
【長そでの季節になって秋終わる冷えてる手には手袋かぶる】
今日の給食&上学ニュース!(12/3)

【さすが!児童生徒会長!昨日の梅干しのお礼をしっかり伝えていました!】

【今日のメニュー】
〇麦ご飯、牛乳
〇石狩汁
〇中華和え

鍋の季節になりましたねぇ・・。今日の給食は、「石狩鍋」をイメージした「石狩汁」でした。味噌で味付けされた、ほくほくのジャガイモや大根、白菜・・・、体が温まりました!

【上学ニュース!】

12月21日(火)の持久走大会目指し、各学年練習に熱が入ってきました。
小学部・・・

【「よ~~~い、スタート!】

【自分のペースで走ればいいんだよ!
 】
】中学部3年生は・・・

【男子3km走、女子2km走を行っていました。】



【トップを独走中!さすが軽やかな走りです!】
「走った距離は裏切らない!」
アテネオリンピックマラソン金メダリスト、野口みずきさんの言葉です。
一歩一歩・・・、目標に向かって歩を進めていきましょう!
頑張ったご褒美でしょう!

【お空からの素敵なプレゼント!
おもちゃランドへようこそ!

2年生が1年生を招待して行った「おもちゃランドへようこそ」
1年生はこの日が来るのを心待ちにしていました。笑顔あふれる交流となった様子をご覧ください。

【会場には、2年生手作りのたくさんのおもちゃが・・・。テンションMAXの1年生です!】

【的待てゲーム!よ~~くねらって!】

【釣りぼりです!大物を狙う子ども達・・・】

【超大物を慎重に慎重につり上げ、大満足!!】
*撮影時のみマスクを外しています。

【ペットボトルボウリングコーナー・・・。そのコースで大丈夫??】

【カーブがかかって、見事ど真ん中に!】

【賞品をゲットしてうれしそう・・・。】


【どんぐりごまコーナー。誰のこまが1番回り続けるかな?
 】
】
【風で走る車で対決!風がちょっと寒い・・・
 】
】
【あ~~
 負けちゃった!】
負けちゃった!】
【優しく見守る2年生・・・。1年生が楽しめるように動いている姿は、頼もしいお兄ちゃんにみえました。】

【うれしそうに金メダルや賞品を見せてくれる1年生。本当に楽しかったようですね!
 】
】
【1年生感想発表:2年生、楽しい時間をありがとうございました!】
今日の給食&上学ニュース!(12/2)

今朝は、青パトのフロントガラスも凍る,今年1番の冷え込みとなりました。
そんな中でも・・・

【半袖で登校するスーパー元気な1年生発見!半袖で通すことが目標だそうです。目標があると人は頑張れるんですね!(でもあまり無理はしないでね!
 )】
)】これからますます寒さが厳しくなります。好き嫌いなく、もりもり食べて元気に過ごしましょう!
ということで・・・
【今日の給食メニュー】
〇麦ご飯、牛乳
〇ホイコーロー
〇卵スープ

【上学ニュース!】


【5/18座論梅、梅ちぎり体験の様子】
あれから、約半年、4年生が収穫した梅は・・・


【真っ赤な梅干しに生まれ変わりました!】
そして・・・

【本日、各クラスにお裾分け・・・】

【ご飯と一緒に・・・】

【おいしく!?いただきました!!
 】
】 切磋琢磨②(相互参観授業より)

相互参観授業、PART2。まずは、1年生音楽「うたでまねっこ」の様子からです。
めあては、「自分たちの歌をもっとよくするには、どうすればよいだろう。」です。

【たくさんの先生が見守る中・・・。がんばれ!1年生!】

【前の時間に撮影した動画を見て、本時の自分たちの表現に生かしていきます。】

【動作も大きく、声も元気になってきたね!】

【歌う表情も素敵になりました!】
では、自分たちの歌をもっとよくしていくには・・・。

【みんなで話し合いながら、素晴らしいまとめが完成しました!】
続いては・・・

中学部1年生数学「平面図形」の学習です。まずは、

【基本作図の復習プリント】

【答えを生徒が説明していきます。】
そして、本題へ・・・。

【何か、楽しそうな問題が提示されました。さぁ、中学1年生諸君!ズバッと解決お願いします!】


【自力解決の時間の後、グループでも話し合います。】

【作図を工夫しながら続々と答えを導き出していました。】

【この生徒の説得力のある説明、見事でした!!】
それでは、教師一人一人の授業力向上を目指す「切磋琢磨」特集、また来週お届けします!
今日の給食&上学ギャラリー!(12/1)
〇チーズパン、牛乳
〇ポークビーンズ
〇アスパラサラダ

今日のサラダには、栄養たっぷりのアスパラガスが入っていました。
新陳代謝を促進するアスパラギン酸は、この植物から発見されたものだそうですよ!

【こ~んなにたくさんのアスパラガスが入っていました!アスパラパラダイス!!
 】
】【上学ギャラリー!】
今日から12月、師走です。公私ともに忙しい時期を迎えます。
「忙しい」は、心が亡くなると書きます。子ども達への気配り、目配りを大切に過ごしていきたいと思います。
さて、今回の上学ギャラリーは、「クリスマス特集」でお届けします。

【まずは、図書館から、思わず手を伸ばしたくなります・・・】

【小学部3年生教室。M先生の手作りです。
 】
】
【
次はギャラリーではないのですが・・・

【ハンドベルクラブの練習風景より・・・】

【何がクリスマスかというと・・・】

【ベレー帽がクリスマスバージョンに!!
 12月9日(木)のクリスマスコンサート楽しみにしています!】
12月9日(木)のクリスマスコンサート楽しみにしています!】寒い1日でしたが、心は温まる光景ばかりでした。
最後に、生徒会長からの気合の入った一言で今日は〆(しめ)です!

【ラストスパートで頑張っていきましょう!】
新聞掲載のお知らせ(12/1)
おめでとうございます!
切磋琢磨①(相互参観授業より)
今週は、4名の先生に授業を提供していただきます。特集でお届けしていきたいと思います。

まずは、小学部2年生算数「図を使って考えよう」の学習からです。

たくさんの先生方が見つめる中、緊張気味の子ども達(担任も?)でしたが、徐々にいつもの力を発揮していきました。


【自分の考えを図にかいて提出!】

【堂々とその式になる理由を説明することができていました。】
続いて3年生です。

社会科「安全なくらしを守る人びとの仕事」の学習です。
学習問題「学校では、火事にそなえてどんな準備をしているのだろうか。」
さぁ!学校内探検です。いくつ消火設備を見つけることができるのでしょうか!?

【防火扉発見!撮影し、後で担任のタブレットへ提出です。】

【消火器は、13個発見しました!(実際は校内に17個あります。

【消火栓】

【「ここにもありました!」なるほど・・非常口ね!】
意欲的に調べていく子ども達・・・。タブレットを使いこなす技能の高さにもビックリです!

【提出された画像を全体で共有】
最後に子ども達と一緒にこの時間のまとめを考えていきました。
まとめ「学校には、火事にそなえて様々な場所に消防設備がある。」
~次回、小学部1年生「音楽」、中学部1年生「数学」の授業の様子をお届けします。お楽しみに!~
親子ふれあい木工教室が開催されました。
2時間弱という短い時間でしたが、『ものづくり』の楽しさを実感していたようです。





理科は感動だ!⑨
まずは、小学部5年生・・・

「ランランラン♪・・ブランコで遊ぶ5年生!」というタイトルでは、ありません!

単元名「ふりこのきまり」の学習です。
かのガリレオ・ガリレイが、揺れるシャンデリアを見ているときに発見したといわれる「振り子の規則性」を、5年生が実験によって解き明かしていきます。

まずは、自らがふりこのおもりとなって体験します。
学習問題「振り子が1往復する時間は何によってかわるのだろうか?」

【体重の違う2人がブランコに乗ると、1往復する時間は変わるのだろうか?】
この日は、導入として身の回りの振り子について体感していきました。
さぁ!!次回、振り子が1往復する時間は、「振り子の重さ」「振れ幅」「振り子の長さ」の、どの条件を変えたとき変わるのでしょうか!?(みなさんはどれだと思いますか?)
続いては・・・

小学部3年生・・・。3年生も外で楽しそうに学習していました。

鏡を持って角度調節中。何しているの?気になる,気になる・・・♪

単元名「光のせいしつ」の学習です!


日光を鏡で反射させたものを集めたり、複数の鏡で反射を繰り返したり・・、意欲的に様々な実験を行っていました。
次回は中学部「理科は感動だ!」特集をお届けします!お楽しみに!
今日の給食&上学ニュース!(11/30)
〇麦ご飯、牛乳
〇宮崎牛の牛丼
〇もやしのナムル

今日の牛丼にはな、な、なんと・・・、宮崎牛が使われていました!さすが宮崎牛、柔らかさやうまみが口いっぱいに広がりました!!

【ど~~と大盛り!うまみやざき!!
 】
】【上学ニュース!】

11月27日(土)、中学部1年生が行う「椎茸の駒打ち」。そのホダ木となるクヌギの伐採作業を行いました。
お忙しい中、しかも休日にもかかわらず、今年も一丁田地区美化委員会の皆様方を中心に作業を進めていただきました。




15本の成木を伐採していきました。
この後、しばらく乾燥させ、約1m20cm位に玉切りし、ホダ木を作っていきます。
そして、肉厚の椎茸(どんこ)ができることを夢見ながら、駒打ち作業を3月に体験する予定です。
今日の給食&上学ニュース!(11/29)
〇セルフバーガー、牛乳
〇コーンスープ

今日は、ハンバーガー。パンにハンバーグ、キャベツ、チーズを挟んで・・・。

【いただきま~す!】
【上学ニュース!】
新型コロナの影響で臨時休業となった場合、いつでもオンラインでの学習保証ができるように、本日4年生が、校内タブレットを持ち帰り、「オンライン授業訓練」を行いました。


今回の訓練(担任の事前準備がしっかりしていたこともあり)、概ねスムーズに流れていきましたが、初めてのことなので、当然いくつかの課題もみられました。(課題を見つけるのも今回の訓練のねらいでした。)今後のオンライン授業へと生かしていきたいと思っています。
新聞掲載のお知らせ(11/27)
「夏の日が秋の空気にバトンパス」
おめでとうございます!
今日の給食&上学ニュース!(11/26)
〇菜めし、牛乳
〇五目うどん
〇もやしと小松菜のソテー

今日は、「ご飯」に「うどん」という「炭水化物祭り!!」。熱や力がわいてきます。


午前中、「期末テスト」で頭をフル稼働させた中学生にとって、エネルギー補給になったことでしょう!
【上学ニュース!】

【イェ~~~イ!!
 】
】朝からハイテンションの4年生です!
今日は、待ちに待った社会科見学です。宮崎科学技術館と県庁に行くそうですよ。

【うれしそうにリュックの中身をみせてくれた少年!
 】
】
【愛情こもったお弁当に、たくさんのおやつ・・・。きっと今頃、みんな仲良く、笑顔で食べていることでしょう!
 】
】 小さな旅⑭(11/26)

【6年生教室にて・・・。2人が眺めているもの。】

【クリスマスツリー
もうそんな季節になるのですね・・・。長かった2学期も残り1ヶ月となりました。
そんな師走間近の上学を旅してみました。
まずは、ツリーつながりで…、

【北風で、たくさん葉っぱが散ってしまい、寂しくなったイチョウの木。でも・・・】

【黄色い絨毯に、子ども達はうれしそう・・・。でも、あまり散らかさないでね・・
 】
】
1年生の学級園では・・・

【「つんつん・・・」何を触っているのかというと・・・】

【フワフワの「綿の木」です!(ツリーつながりで…
 )去年の種子を試しにまいたところ、立派に成長したそうです。収穫した種子は、また来年の1年生に受け継がれることでしょう!】
)去年の種子を試しにまいたところ、立派に成長したそうです。収穫した種子は、また来年の1年生に受け継がれることでしょう!】続いては、秋から冬へ、季節を感じる光景です。


【干し柿です!あま~く、あま~く、あまくなれ~!
 】
】
【人権の花の水やりをしている5年生。これから水が冷たくなるけど、よろしくお願いします!】
小さな旅PART14~「FIN」~
今日の給食&上学ニュース!(11/25)
〇麦ご飯、牛乳
〇真鯛のスープカレー
〇にんじんドレッシングサラダ

スープカレーは、サラサラしているので、どうやって食べるのだろうと子ども達に注目していたら・・・。(放送では、ご飯をスプーンですくって、スープに浸して食べることをすすめていましたが・・・)


【私は、ご飯にかけて食べた方が好きです!(という子どもが多かったようですね!私もです!
 )】
)】【上学ニュース!】

今日から中学部は期末テスト・・・。初日は「英語」「理科」「保体」のテストでした。みんな、よい点数を取ろう!と真剣に取り組んでいました。

【1校時、テスト勉強に取り組む中学部2年生】


【やれば~~~、できる!!FIGHT!
 】
】次のニュースです!

本日、小学部「給食試食会」が行われました。昨年度は、新型コロナウィルスの影響で中止になったので、2年ぶりの開催とないます。

【栄養教諭の講話】


【各教室給食準備参観&給食試食】
お忙しい中参加していただいた保護者の皆様、給食に関する貴重なご意見をいただき、ありがとうございました。
授業の様子SP②

5年生家庭科「ご飯を炊こう」です。


【炊き上がるまでをタブレットで撮影し研究中!さぁ、上手に炊き上がったのでしょうか!?】

【ふっくら、ほかほか・・・】

【おいしく炊き上がりました!宿泊学習の体験が生きていますね!ちょっとおこげもできていておいしくいただきました。】
授業の様子SP、最後は・・・

【中学部3年生「バレーボール」の様子です。体育の授業とは思えない、レベルの高さにビックリ!】

【男子も女子も、強烈なスパイクがコートに突き刺さっていました!
 】
】授業の様子SP「おしまい!」
今日の給食&上学ニュース!(11/24)
〇揚げパン、牛乳
〇ポトフ
〇ハムサラダ
〇ミカンクレープ

今日は見ての通り、子ども達が喜びそうなメニューが並んでいます。
富田小学校6年生のリクエスト献立です。
その中でも人気NO.1だったのは、もちろん・・・

【揚げパンです!】

子ども達の気分もアゲアゲ、きな粉を口いっぱいにつけ、おいしそうに頬張っていました。】
【上学ニュース!】
11月24日(水)、火災を想定した避難訓練を行いました。
めあては、「自分の命は自分で守る」です。訓練の様子をご覧ください。


【火元から離れた経路を選択し、素早く避難】


【東児湯消防組合新富分遣所の方のお話】


【水消火器訓練】

【生活美化委員会お礼の言葉】

これから空気が乾燥し、火災の発生しやすい季節となります。まずは、「火遊びをしない!」そして、もし発生した場合は、今日の訓練を生かして「自分の命は自分で守る!」行動を取ってもらいたいと思います。
授業の様子SP①

イチョウの葉も黄色く染まり、秋から冬へと移りゆく上学です。
さて、今回は、ここ最近の授業の様子をSP(スペシャル)特集でお届けしていきます。


【まずは6年生図工・・・。彫刻刀を使って一生懸命版木を彫っていました。何を彫っているのでしょう???】

【年賀状ですね!刷り上がりが楽しみです!】


【墨付け、着色と進み・・・。さぁ、どんな作品に仕上がったのでしょうか!?】


【子ども達一人一人がイメージする個性あふれる虎が誕生しました!でも、夢中になりすぎて・・・】

【みんな、手はこんな感じに・・・】
続いては・・・

1年生図工「紙粘土を使って」

【楽しそう・・・
 何ができあがったのかな?】
何ができあがったのかな?】
【お~~、ソフトクリームですね!おいしそう・・・】

【ドーナツにケーキにクッキーに・・、みんなお腹減ってたのかな?
 】
】まだまだ続きます。

小学部3年生体育「ボール運動」です。

【円陣パス、何回続けられるかな?】

【ナイスレシーブ!!】
PART2へ「つづく」
ふるさと農業体験学習(中学部1年)
目的は「農業体験学習を通して、ふるさとの基幹作業である農業についての理解を深めること」です。
では、体験の様子を写真を中心に紹介していきます。


【吉田農園:ニラの選別(すぐり)作業体験】


【勝川農園:ブロッコリーの収穫(種まき体験もしたそうです。)】


【神田農園:ズッキーニの収穫体験】


【大﨑牧場:牛の餌やり体験】


【猪股農園:ニラの収穫・包装等、出荷準備作業】


【有田牧場:牛についての話や牛舎の掃除、子牛への授乳体験等】
この体験を通して、ふるさとの農業に対する理解を深めることができ、「地域について知る」よい機会となりました。また、就農されている方の、農業に対するへの熱い思いを聞くことができ、キャリア教育の推進にもつながりました。
協力していただいた地域の皆様、誠にありがとうございました。
今日の給食&上学ニュース!(11/22)
〇米粉パン、牛乳
〇野菜ミートソース
〇海藻サラダ


ミートソースに使われている豚肉には、ビタミンB1がたくさん含まれています。
ビタミンB1が不足すると、やる気が起こらず体がだるくなったり、少しの運動でも息切れしたりするそうです。
持久走の練習も始まります。たくさん食べて元気に過ごしていきましょう!
【上学ニュース!】

11月19日(金)、17:30、職員が眺める先ににあるものは・・・

お月様・・・。当然これは三日月ではありません。
140年ぶりに見られた「部分日食」(ほぼ皆既月食)です。

17:50、こんなに小さく・・・

部活終わりの生徒も加わり、時間とともに欠けていく月を見上げ、感動の声を上げていました。
次回、全国で食の最大が観測できるのは、なんと65年後・・・。2086年11月21日だそうです!

中学部2年修学旅行特集(最終回)
解散式の様子です。
あっという間の2泊3日でした。「みんなで学び合い、団結して、一生の思い出に残る修学旅行にしよう」というスローガンのもと、多くのことを見て、聞いて、学ぶことができたと思います。
これで、修学旅行特集は終わりです。見てくださった方々ありがとうございました。
到着予定は、18時です。
中学部2年修学旅行特集⑱


14時25分に「グリーンランド」を出発しました。
今日の給食&上学ギャラリー(11/19)
〇麦ご飯、牛乳
〇みそけんちん汁
〇さばみぞれ煮(ゆかり和え)


【↑さばのみぞれ煮】
「みぞれ」がつくものは、大根おろしを使った料理のことを言うそうですよ!
甘辛く煮込んであり、ご飯がすすみました。
【上学ギャラリー】

5年生の作品が展示されていました。テーマは、「消してかく」???
コンテやパステルで塗り込んだ画面を消しゴムや練り消しで消して表現していました。

【タイトル「夜道を歩くねこ」】

【タイトル「ふしぎな宇宙」】

【タイトル「自分の宇宙」】
宇宙といえば・・・

【令和3年9月22日、十五夜お月様より・・・】
本日、140年ぶりに起こる天体ショーが見られそうですね!
約98%が隠れるという、限りなく皆既に近い部分月食です。月食の継続時間は、過去300年で最長レベルだそうです。もうワクワクが止まりません!
夕方18:02、食が最大になるそうです。ちょうど中学2年生修学旅行の帰校予定時刻です。一緒に見るのを楽しみにしています!

手洗いのすゝめ・・(小学2年生)


小学部2年生学級活動「みんなで手洗い」の授業の様子です。

【めあては、「手洗いの大切さを考えよう」】
まず・・・

先生に、特別なクリームを塗ってもらい・・・

【びっくり箱のような箱に手を入れてみると・・・】

【「なんじゃこりゃ!!
 」LEDブラックライトに照らされて、クリームを塗った部分が真っ白に!!】
」LEDブラックライトに照らされて、クリームを塗った部分が真っ白に!!】この白い部分を汚れやウィルスだと仮定して・・・

【早速、手洗い開始!!】

【しっかり石けんをつけて・・・】


【「手洗いアワアワ体操」を実践!さぁどのくらい汚れが落ちたかな?】

【再び見てみると・・・】


【After:かなりきれいになりました!(でも、指の間や手の甲にまだ白い部分が・・・)】
どの部分に汚れやウィルスが残りやすいのか、実感した2年生です。
そして、この後(授業が4校時だったので)、給食です。清潔になった手で、気持ちよく・・・


【「いただきま~~す!」
中学部2年修学旅行特集⑰
8時45分「太宰府天満宮」到着
【集合写真】
「はい、チーズ 目をパッチリ」
【参拝場まで歩きました】
参拝時に、5円、15円、50円、といくらお賽銭を入れるか悩んでいました。「ニ礼、ニ拍手、一礼」をきちんと行い、名前と住所、願い事を心の中で唱えていました。
【自由タイム】
お守りを買ったり、おみくじを引くなどしました。おみくじの結果を聞くと「大吉」の生徒が多くてビックリでした。
中学部2年修学旅行特集⑯
おはようございます。6時起床です。
ついに、修学旅行最終日を迎えました。今日も学び、楽しんでいきます。
6時50分「朝食」です。
【和食でした】
7時55分「退館」です。
【お世話になりました】
今は、「太宰府天満宮」に向かっています。みんな元気です。
中学部2年修学旅行特集⑮
18時10分「原鶴グランドスカイホテル」到着
実は、バスガイドさんの考えてくださったクイズの中で何時にホテルに着くかをみんなで予想しようという遊びをしました。実際には、18時8分に着きました。当たった人の発表は、明日するようです。お楽しみに。
入館式の後すぐに、本日の夕食です。
【洋食でした】
【みんなしっかり食べていました】
本日の特集は以上となります。本日も充実した1日となりました。みんながメリハリのある行動をしてくれたおかげで、時間通りに進むことができました。みんな元気です。
中学部2年修学旅行特集⑭
15時10分「マリンワールド海の中道」到着
【集合写真】
「はい、チーズ ギョー」
【アシカ・イルカショー】
【お土産タイム】
家族のはもちろん、自分にも買っていました。大きめのぬいぐるみを買った人もちらほら…
【どこにいる?】
17時30分現在、ホテルに向かっています。バスの中では、ガイドさんとジャンケン大会やマジカルバナナなどをして過ごしてます。たくさん動きましたが、みんなまだ元気が有り余ってるようです。
中学部2年修学旅行特集⑬

※撮影禁止のため生徒達の写真はありません。
この修学旅行では、事前学習で平和学習を進めていました。
たくさんの資料をじっくり見て、メモをして、改めて戦争の恐ろしさや自分や大切な人の命の重さを感じていました。
心にも花を咲かせましょう・・(11/18)

11月18日(木)、人権委員会と各学級の代表者で「人権の花」後期の植栽を行いました。

【苗の植え方を説明する6年生】
植え方が分かったら・・・、

【みんなで植えましょう!!
 】
】
【植えるお花は、「パンジー」「キンギョソウ」「ノースポール」です!】


【下級生には、中学生や6年生が優しく手伝ってくれます。】

【上手に植えることができて満足気な小学部1年生・・・】
これから、水やり等のお世話を続けていき、卒業式・入学式でお披露目する予定です。

【子ども達の心にも美しい花が咲きますように・・・】
植栽終了後・・・



【道具の片付けや水やりを進んでやってくれていた中学生。(さすが心が育っていますね!!)】
11月④12月①
今年も最後の1か月…1年が経つのは早いですね。11月の終わりから、身体を温めるメニューが多くなってきました。おでんにポタージュ、豚キムチ丼です!チリコンカンも給食によく出るメニューの一つですね。メキシコ風のアメリカ料理です。チリコンカンはスペイン語で「チリコンカルネ」と呼ばれ、「チリ」は「唐辛子」、「コン」は「と」、「カルネ」は「牛肉」という意味があります。名前の通り牛ひき肉をチリで煮込んだ料理で、そこに定番食材の豆やトマトを入れ、栄養バランスの良いメニューとなっています。(給食には、唐辛子は入っていません。)献立表を見るとき、メニュー欄だけでなく、使われている食材や調味料の欄もぜひ見てほしいと思います(*^_^*)
11月①ヴィアマテラスの選手と(*^^*)
11月5日(水)は、ヴィアマテラス宮崎の選手が9名来校し、子どもたちと一緒に給食を食べました。この日のメニューは「米粉パン、牛乳、秋のかおりシチュー、花野菜サラダ」でした。シチューの中には、秋を代表するさつまいもやしめじがたっぷり入っていました。選手や学級の仲間と食べる給食はとてもおいしかったですね!一人で食事をするより、食事をする相手がいる方がより幸せを感じるそうです(*^▽^*)給食の後は、選手と一緒に運動場でサッカーをしたりおにごっこをしたり、みんなで楽しい時間を過ごすことができました!
9月③④⑤
9月後半の給食です。みんなが大好きなポークカレーにバーガーパン、豚キムチ丼!イタリアンスープの中には、ラビオリが入っていました。(ラビオリとは、パスタ生地の中にひき肉や野菜、チーズなどを挟んだものです。)そして、9月最後の日には「うなぎのかば焼き」が出ました(*^^*)今年も中村養鰻場さんからの提供により、おいしいうなぎを食べることができました。ありがとうございました。栄養価の高いうなぎは、体育大会の練習をがんばっている子どもたちにぴったりの食材です。今日から10月…体育大会までのこり2週間です!(^^)!早寝早起き・朝ご飯はもちろんのこと、バランスのよい食事を心がけて、万全の体調で臨みましょう!
7月③★夏休みがはじまるよ!★
7月最後の週は、チャンポンにホットドックパン!シメは、夏野菜カレー(^_^)なすやピーマンがたくさん入っていました。おいしい給食を毎日ありがとうございました。みんなもりもり給食を食べているかなと教室をのぞいてみると、上新田から転校する子と別れを惜しんで、みんなで給食を食べている姿が見られました。さびしいですね…でもきっと新しい学校でもがんばってくれることでしょう。上新田っ子、みんなで応援していますよ!(8月の給食へとつづく~)
7月①②~給食試食会~
夏休みまで、のこり1週間…子どもたちは、厳暑の中よくがんばっています。7月に入って、季節にちなんだ花野菜サラダや七夕ゼリーが出ました。涼を感じるメニューでしたね。7月10日(木)は、給食試食会が行われ、保護者の皆様に学校給食の献立や味、栄養を知っていただく機会となりました。今年も新田学園の栄養教諭・渡部先生を講師としてお招きし、給食の栄養バランス等についてお話していただきました。保護者の皆様は「毎日、給食食べたいね。」「おいし~い!」と笑顔いっぱいでした(*^_^*)今週は、子どもたちが大好きなホットドック、そして夏野菜カレーで1学期をしめくくります。登校するのもあと4日!元気に過ごしましょう~
〒889-1406
宮崎県児湯郡新富町大字新田17053番地8
電話番号(小)0983-35-1016
(中)0983-35-1017
FAX (小)0983-35-1305
(中)0983-35-1286
E-mail 4520ja@miyazaki-c.ed.jp
本Webページの著作権は、「学びの丘 上新田学園」が有します。無断で、文章・画像などの複製・転載を禁じます。
【校訓】

| 日 | 月 | 火 | 水 | 木 | 金 | 土 |
1 | 2 | 3 | 4 | 5 | 6 | 7 |
8 | 9 | 10 | 11 | 12 | 13 | 14 |
15 | 16 | 17 | 18 | 19 | 20 | 21 |
22 | 23 | 24 | 25 | 26 | 27 | 28 |
29 | 30 | 31 | 1 | 2 | 3 | 4 |

















